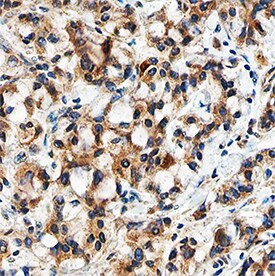
TGF beta-3 Antibody in Immunohistochemistry (Paraffin) (IHC (P))

Search
Invitrogen
TGF beta-3 Monoclonal Antibody (20724)
{{$productOrderCtrl.translations['antibody.pdp.commerceCard.promotion.promotions']}}
{{$productOrderCtrl.translations['antibody.pdp.commerceCard.promotion.viewpromo']}}
{{$productOrderCtrl.translations['antibody.pdp.commerceCard.promotion.promocode']}}: {{promo.promoCode}} {{promo.promoTitle}} {{promo.promoDescription}}. {{$productOrderCtrl.translations['antibody.pdp.commerceCard.promotion.learnmore']}}
图: 1 / 2
TGF beta-3 Antibody (MA5-23812) in IHC (P)


Please note: We are reviewing Western blot images included in the antibody testing data in our catalog, including those provided by third parties. Unless expressly labeled or annotated as “raw-unedited”, Western blot images included in the antibody testing data in our catalog may have been edited, optimized or otherwise adjusted for presentation.
产品信息
MA5-23812
种属反应
已发表种属
宿主/亚型
分类
类型
克隆号
抗原
偶联物
形式
浓度
规格
纯化类型
保存液
内含物
保存条件
运输条件
RRID
产品详细信息
In Western blots, less than 25% cross-reactivity with recombinant human (rh) TGF- beta 1.2 and rhTGF-beta 2 is observed, and less than 2% cross-reactivity with recombinant amphibian TGF-beta 5 and recombinant human TGF-beta 1 is observed. This antibody neutralizes the biological activity of TGF-beta 3 but not TGF-beta 1, TGF-beta 2, or TGF-beta 5.
Reconstitute at 0.5 mg/mL in sterile PBS.
Endoxin level is <0.10 EU per 1 µg of the antibody by the LAL method.
靶标信息
Transforming growth factor beta 3 (TGF beta 3) is the third member of the transforming growth factor family of cytokines, which also includes TGF beta 1 and beta 2. These cytokines are secreted in precursor form consisting of a bioactive C-terminal domain attached to an N-terminal domain known as latency associated protein (LAP). Cleavage of LAP results in the mature protein, which functions as a disulfide-linked homodimer. As with all members of the family, TGF beta 3 is highly conserved across species, with mouse and human TGF beta 3 demonstrating 100% sequence homology and cross-species activity.The members of this family can be expressed by most cell types and exert pleiotropic effects, which include the suppression of B- and T-cell effector activity, mediation of tissue healing, and suppression of tumor proliferation. The promotion of CD4+CD25+ T-cell expansion is a newly discovered function of the TGF beta cytokines, and indicates an important role in the protection against autoimmunity.
仅用于科研。不用于诊断过程。未经明确授权不得转售。
生物信息学
蛋白别名: FLJ16571; H-TGF-b-3; tgf beta 3; TGF-beta-3; Transforming growth factor; transforming growth factor beta-3; Transforming growth factor beta-3 proprotein
基因别名: TGF-B3; Tgfb-3; TGFB3
UniProt ID: (Rat) Q07258
Entrez Gene ID: (Rat) 25717, (Mouse) 21809